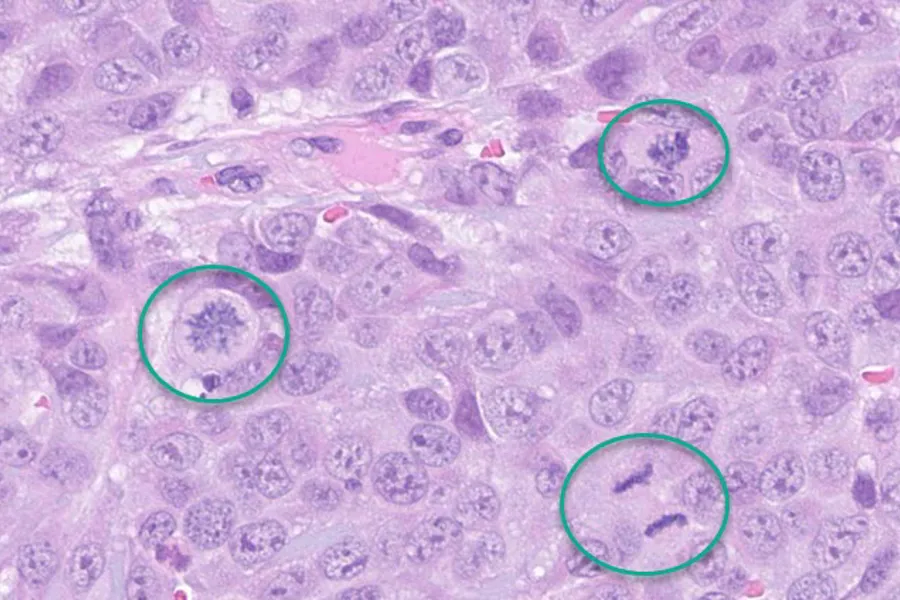
Bakgrunn mønster

Automatic classification of skin lesions
Skin cancer is the cancer type with the largest increase in incidence the last decade, the incidence of skin cancer in Rogaland is currently amongst the highest in the world. Since 1951 the incidence in Norway has increased almost 13 times from 2.9/100,000 to 38.4/100,000. In 2017, 2222 new cases were diagnosed and 306 died of the disease. Malignant melanoma is more aggressive than most other types of skin cancers and other cancers in general. If not treated early, the tumor is likely to thicken and progress to another stage and can invade into nearby lymphatic -or blood vessels and can spread fast to other parts of the body.
This work package aims to develop a Computer-aided Diagnostic (CAD) system for whole slide images that will help pathology departments to diagnose malignant melanoma more efficiently by:
- Separating truly benign lesions from all other lesions
- Reducing examination time by automated marking of possible malignant area’s
- Reducing diagnostic variations by training CAD on malignant lesion recognition
- Increase diagnostic accuracy by developing machine learning (ML) algorithms for predicting prognosis
- Adapting ML algorithms by adding molecular data can refine these algorithms even more

Overview of the proposed system which comprises of three main steps; 1. Convolutional neural network analysis of the whole slide image; 2. Digital image processing; 3. Feature based decision
The following figure shows a collection of images from a benign melanocytic lesion and a malignant melanoma. Some typical histological features are highlighted in red. These features are currently being used by pathologists in daily practice to differentiate between benign and malignant lesions.

